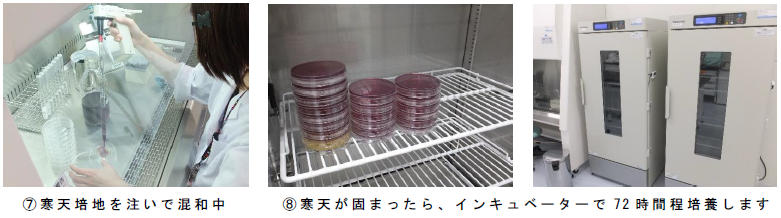

2014/03/30
No. 13 「Gパン から ジーンズ そして デニムへと…」
思いつきラボ
2014/03/15

繊維業界は歴史が長く、また、川上から川下までサプライチェーンが長いため、立場が異なるだけで言葉づかいや慣習が異なります。 「思いつきラボ」では、繊維に関するちょっとした疑問や面白話などをご紹介します 。
※2014年3月15日時点の内容です。
ニュース報道で「白い割烹着(かっぽうぎ)売れ行き急増」の見出しが目にとまり、記事を読むと、今何かと物議を醸(かも)している万能細胞「STAP細胞」の研究発表後からとあります。「STAP細胞」論文の信憑性(しんぴょうせい)については今後の動向を見守りたいと思いますが、研究員が着用していたことで、存在感としては地味だった割烹着が脚光を浴びることとなりました。我々の検査業務担当者も白衣を着用しているのですが、確かに前ボタンより後ろで留める割烹着のほうが汚れよけの意味合いからは理に適(かな)っていると思います。
オシャレ感がないとして昭和の高度成長期からずっとエプロンに押され気味になっていたのが、オシャレ商品としてまた注目を浴びることになりました。これからの研究員たちはみんな割烹着に・・・ということにはなりませんが、しばらくはブームになればと思っています。日本伝統の衣料品が注目を集めるのは気分のいいものです。
「再生細胞」研究とはいきませんが、思いつきラボでもなにかそれ風な自由研究がないものかと探していたところ、立石バイオケミカルのメンバーより乳酸菌飲料の乳酸菌を調べてみましょうという提案が・・・即採用です。
ということで・・・・・・・・
細菌は目に見えないほど微細な生物です。では、どうやって数えることができるのでしょうか?微生物実験においては様々な測定方法があります。今回は混釈平板培養法を用いて生菌数測定をしましょう。
混釈平板培養法とは、検体あるいは希釈した検体をシャーレに採り、液状の寒天を加えて混合します。これを冷まし、固まったらインキュベーターで培養します。培養後に形成されたコロニー(集落)の数を数えて、もとの検体の菌数を算出する方法です。

検体を寒天と混ぜる。この状態だと菌は目に見えないぐらい小さいので、目に見える大きさのコロニー(集落)になるまで培養する。(1個の細菌が増殖して1つのコロニーを形成する)
もう少し詳しい手順を例で見てみましょう。

検体(20mL)中の生菌数を3200個とします。

①よく撹拌した検体から1mL シャーレに取り出して寒天と混ぜます。
3200個/ 20mL より 1mL 取り出しているので、シャーレ中には 160個の菌がいる状態になります。
160 個/ mL
②寒天が固まったら培養し、形成されたコロニーを数えます。
寒天上には160 個の菌がそれぞれにコロニーを形成して、目で見て確認できるようになっています。
※菌液中の生菌数が多いまたは多いと推測される 場合
上記のほかに、希釈系列を作って数えます。
希釈系列とは、段階的に薄めた液のことです。

コロニー数が30~300 個の平板を採用し、菌数を算出します。この場合の検体 1mL あたりの菌数は、希釈倍率の 1000 をかけて、
43 個× 1000 43,000 個/ mL
ちなみに、検体が20mL の場合、検体全部では、
43,000 個/ mL × 20mL=860,000 個/ 20mL
となるのです。
用意するもの
・乳酸菌飲料 ・生理食塩水
・試験管 ・シャーレ
・寒天培地 ・マイクロピペット

培養後のようすは・・・
見事に乳酸菌のコロニーが形成されていました!この寒天培地には、乳酸菌が培地の栄養分を分解して生成する乳酸に反応して、黄色に変色するものを使用しています。

実際の結果です。

乳酸菌飲料とは、乳などを乳酸菌又は酵母で発酵させたものを加工し、又は、主要原料とした飲料のこ
とをいい、はっ酵乳とは、乳又はこれと同等以上の無脂乳固形分を含む乳などを乳酸菌又は酵母で発
酵させ、糊状又は液状にしたもの又はこれらを凍結したものをいいます。
今回の実験では乳酸菌を確認できたわけですが、身の回りには多くの菌類が存在しています。菌というと何かと害のあるもの、避けるものと思われていますが、乳酸菌のように食文化に深く関わっているものや、古くから生活の役に立ってきた菌類も多いのです。日頃なかなか目には見えないものですが、うまく付き合っていくことが大切ですね。

・・・・・・・なんとも素晴らしい自由研究になりました。乳酸菌は腸などの消化管にバランスよく存在していることで、腸内環境の正常化を維持しようと努めてくれている役に立つ菌なのです。今回の報告で乳酸菌もより身近なものになりました。
自由研究協力者のみなさんありがとうございました。
また自由研究テーマや質問などお待ちしております。
原稿担当:立石ラボ 神﨑 江麻・ 竹中 直(チョク)
自由研究協力者:立石ラボ 村田 貴洋・湯沢 拓也・戸谷 佑衣、蔵前ラボ 中西 つばさ
PDF版はこちらから
お問い合わせ
一般財団法人ニッセンケン品質評価センター
防災・安全評価グループ グループ長
竹中 直(チョク)
E-mail: bosai_anzen@nissenken.or.jp
思いつきラボ
各種お問い合わせCONTACT
サービス全般についてのお問い合わせ
![]()
各種試験・検査に関するお問い合わせ、ご依頼はこちらから承ります。
エコテックス®に対するお問い合わせ
![]()
エコテックス®認証に関するお問い合わせ、ご依頼はこちらから承ります。
技術資料ダウンロード
![]()
各種試験・検査に関する技術資料が、こちらからダウンロードいただけます。
よくあるご質問
![]()
試験・検査などで、皆さまからよくいただく質問と回答をまとめています。
お電話からのお問い合わせはこちら